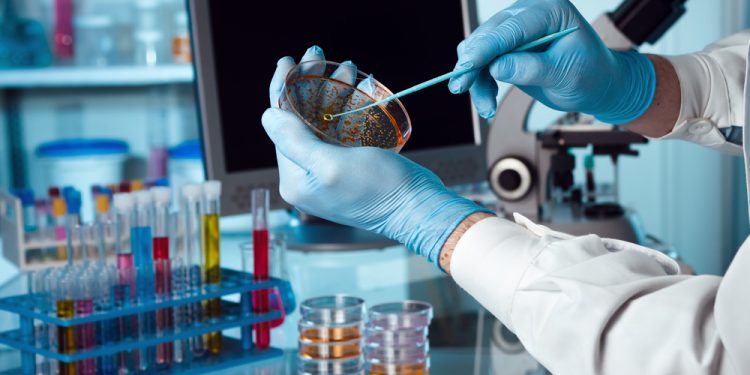

El Centro de Investigación en Alimentación y Desarrollo (CIAD) realiza una investigación sobre el dengue y la rickettsia financiada por CONACYT, así lo informó el Dr. Rogelio Sotelo en entrevista para Soledad Durazo en Fórmula.
Primeramente, mencionó que los niveles de transmisión de estas enfermedades dependen de la prevención de los ciudadanos.
“Definitivamente el clima, la humedad afectan estos aspectos de la reproducción del vector y después vienen los brotes de la enfermedad”, dijo.
También explicó que desde el CIAD buscan contrarrestar estas enfermedades participando en campañas a nivel municipal sobre limpieza e higiene, su intervención además es desde aspectos moleculares con métodos de diagnóstico.
De acuerdo con las investigaciones realizadas se determinó que las poblaciones vulnerables en Sonora se encuentran en mayor riesgo de poder adquirir este tipo de enfermedades, al no conocer las medidas de prevención.
Se busca desarrollar compuestos naturales para eliminar bacterias, hongos, menos tóxicos para humanos y evitar que las plagas desarrollen resistencia.
Finalmente mencionó que se encuentran en el primer paso de investigación de respuesta molecular de la garrapata en perros y actualmente cuentan con un protocolo aprobado para identificar poblaciones con este tipo de problemáticas.
Puedes encontrar la entrevista disponible en Soledad Durazo en Spotify.